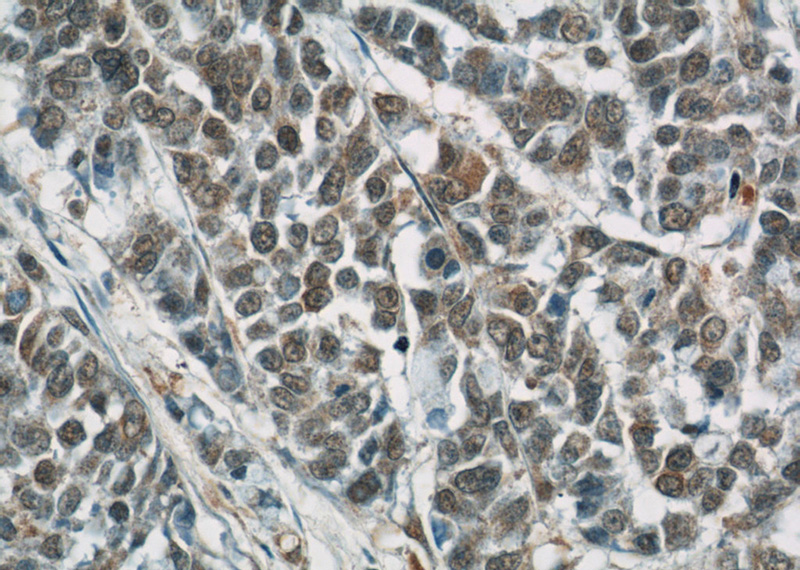
Immunohistochemical of paraffin-embedded human colon cancer using Catalog No:108005(AREG antibody) at dilution of 1:50 (under 40x lens)

-
Product Name
Amphiregulin antibody
- Documents
-
Description
Amphiregulin Rabbit Polyclonal antibody. Positive FC detected in HeLa cells. Positive IF detected in Hela cells. Positive IHC detected in human colon cancer tissue, human breast cancer tissue, human colon tissue, human skin tissue. Positive WB detected in MCF7 cells, HepG2 cells. Positive IP detected in HepG2 cells. Observed molecular weight by Western-blot: 28-50 kDa
-
Tested applications
ELISA, IF, WB, IHC, FC, IP
-
Species reactivity
Human; other species not tested.
-
Alternative names
amphiregulin antibody; AREG antibody; AREGB antibody; CRDGF antibody; SDGF antibody
- Immunogen
-
Isotype
Rabbit IgG
-
Preparation
This antibody was obtained by immunization of Amphiregulin recombinant protein (Accession Number: NM_001657). Purification method: Antigen affinity purified.
-
Clonality
Polyclonal
-
Formulation
PBS with 0.02% sodium azide and 50% glycerol pH 7.3.
-
Storage instructions
Store at -20℃. DO NOT ALIQUOT
-
Applications
Recommended Dilution:
WB: 1:1000-1:10000
IP: 1:1000-1:10000
IHC: 1:20-1:200
IF: 1:10-1:100
-
Validations

MCF7 cells were subjected to SDS PAGE followed by western blot with Catalog No:108005(AREG antibody) at dilution of 1:2000

Immunohistochemical of paraffin-embedded human colon cancer using Catalog No:108005(AREG antibody) at dilution of 1:50 (under 10x lens)
Immunohistochemical of paraffin-embedded human colon cancer using Catalog No:108005(AREG antibody) at dilution of 1:50 (under 40x lens)

Immunofluorescent analysis of Hela cells, using AREG antibody Catalog No:108005 at 1:25 dilution and Rhodamine-labeled goat anti-rabbit IgG (red).

IP Result of anti-AREG (IP:Catalog No:108005, 4ug; Detection:Catalog No:108005 1:2000) with HepG2 cells lysate 3600ug.

1X10^6 HeLa cells were stained with .2ug AREG antibody (Catalog No:108005, red) and control antibody (blue). Fixed with 90% MeOH blocked with 3% BSA (30 min). FITC-Goat anti-Rabbit IgG with dilution 1:100.
-
Background
Amphiregulin (AREG) is one of the ligands of the epidermal growth factor receptor (EGFR). AREG plays a central role in mammary gland development and branching morphogenesis in organs and is expressed both in physiological and in cancerous tissues. The AREG protein is synthesized as a 252-amino acid transmembrane precursor, pro-AREG. At the plasma membrane, pro-AREG is subjected to sequential proteolytic cleavages within its ectodomain and is then released as the soluble AREG protein. Depending on the cell type and microenvironment, AREG can be produced in multiple cellular and mature forms using alternative pro-AREG cleavage sites and glycosylation motifs. Post-translastional modfications of 50-kDa pro-AREG produces a major soluble 43-kDa form, 28-, 26-, 16-kDa membrane anchored forms, and soluble 21-, 19-, and 9-kDa forms (PMID: 9642297).
-
References
- Yang N, Morrison CD, Liu P. TAZ induces growth factor-independent proliferation through activation of EGFR ligand amphiregulin. Cell cycle (Georgetown, Tex.). 11(15):2922-30. 2012.
- Stoll SW, Stuart PE, Swindell WR. The EGF receptor ligand amphiregulin controls cell division via FoxM1. Oncogene. 2015.
- Stoll SW, Stuart PE, Lambert S. Membrane-Tethered Intracellular Domain of Amphiregulin Promotes Keratinocyte Proliferation. The Journal of investigative dermatology. 136(2):444-52. 2016.
Related Products / Services
Please note: All products are "FOR RESEARCH USE ONLY AND ARE NOT INTENDED FOR DIAGNOSTIC OR THERAPEUTIC USE"
